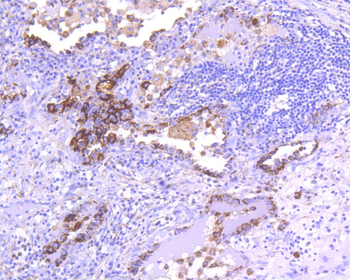
CD63 Recombinant Rabbit Monoclonal Antibody

You have no items in your shopping cart.
- Cyclin D3 Recombinant Mouse Monoclonal Antibody [orb1172536]
ICC, WB
Human, Rat
Human, Rat
Mouse
Recombinant
Unconjugated
25 μl, 100 μl, 50 μl - Featured
CD63 Recombinant Rabbit Monoclonal Antibody [orb1151946]Featured
ICC, IF, IHC-Fr, IHC-P, WB
Human
Rabbit
Recombinant
Unconjugated
50 μl, 100 μl, 25 μl - Featured
Mesothelin Recombinant Rabbit Monoclonal Antibody [orb1151988]Featured
IF, IHC-Fr, IHC-P, WB
Human
Rabbit
Recombinant
Unconjugated
25 μl, 100 μl, 50 μl - Featured
FGFR2 Recombinant Rabbit Monoclonal Antibody [orb1151992]Featured
IF, IHC-Fr, IHC-P
Human, Mouse, Rat
Mouse, Rat
Rabbit
Recombinant
Unconjugated
25 μl, 100 μl, 50 μl - PCK1 Recombinant Mouse Monoclonal Antibody [orb1172783]
IF, IHC-Fr, IHC-P, WB
Human, Rat
Human, Rat
Mouse
Recombinant
Unconjugated
25 μl, 100 μl, 50 μl - GPNMB Recombinant Mouse Monoclonal Antibody [orb1172546]
ICC, IF, IHC-Fr, IHC-P, WB
Human, Rat
Rat
Mouse
Recombinant
Unconjugated
25 μl, 100 μl, 50 μl - UGDH Recombinant Mouse Monoclonal Antibody [orb1172825]
ICC, IF, IHC-Fr, IHC-P, WB
Human
Mouse, Rat
Mouse
Recombinant
Unconjugated
25 μl, 100 μl, 50 μl - ALDOA Recombinant Rabbit Monoclonal Antibody [orb1172784]
ICC, IF, IHC-Fr, IHC-P, WB
Human, Mouse, Rat
Mouse, Rat
Rabbit
Recombinant
Unconjugated
25 μl, 100 μl, 50 μl - ABCE1 Recombinant Rabbit Monoclonal Antibody [orb1173011]
FC, ICC, IF, IHC-Fr, IHC-P, IP, WB
Human, Mouse, Rat
Mouse
Rabbit
Recombinant
Unconjugated
25 μl, 100 μl, 50 μl - ACVR1B Recombinant Rabbit Monoclonal Antibody [orb1173036]
ICC, WB
Human, Mouse
Human, Mouse
Rabbit
Recombinant
Unconjugated
25 μl, 100 μl, 50 μl